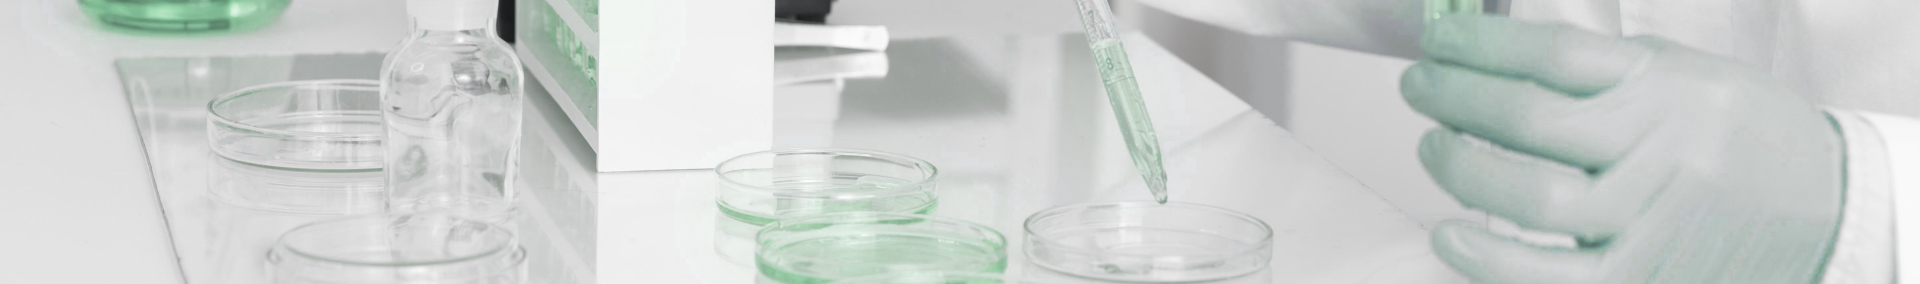

Programas de Investigación
P01. INVESTIGACIÓN CLÍNICA, EPIDEMIOLÓGICA, SOCIOSANITARIA Y ENSAYOS CLÍNICOS
Fundamentación
Este Programa de Investigación está diseñado en forma escalonada desde la educación sanitaria del individuo al ensayo clínico, profundizando en los aspectos de empoderamiento que la sociedad actual y la sostenibilidad del sistema público de salud demandan. Los estudios epidemiológicos permitirán una actualización de la realidad de la prevalencia de factores de riesgo en salud y enfermedades crónicas en nuestra Comunidad, pero también la situación social económica y cultural que tiene demostrada influencia en la determinación de la salud y la enfermedad. Todo ello permitirá establecer y sugerir políticas sociales que favorezcan la educación para la salud (aspectos incluidos en la Línea Estratégica 03), hábitos de vida saludables que incluyan la práctica de actividad física, alimentación adecuada y control de la obesidad. Otro aspecto de importancia lo constituye la realización de ensayos clínicos alineados con grupos internacionales en la investigación de los nuevos tratamientos que la lucha contra la enfermedad demanda. También abordará la educación sanitaria en aspectos metodológicos esenciales.
Líneas de Investigación
01. Farmacología Clínica (Ensayos Clínicos, Farmacovigilancia, Concentraciones de Fármacos).
02. Epidemiología y Farmacoepidemiología.
03. Investigación Clínica y Ensayos Clínicos en Enfermedades Respiratorias
04. Prevalencia de factores de riesgo cardiovascular: hipertensión arterial, dislipemias, diabetes, tabaquismo, obesidad, sedentarismo.
05. Incidencia de eventos cardiovasculares en cohorte poblacional HERMEX.
06. Entorno social, económico y cultural de la enfermedad cardiovascular.
07. Educación en salud, importancia del conocimiento de la enfermedad por la población.
08. Educación en salud, importancia del conocimiento de la enfermedad cardiovascular por la población.
09. Educación en salud a sanitarios. Alta y seguimiento del paciente crónico.
10. Estilos de vida saludables al paciente crónico privilegiando actividad física y alimentación.
11. Prevalencia y relevancia de las comorbilidades en la insuficiencia cardíaca (neoplasias, insuficiencia renal crónica, anemia, EPOC, etc.).
12. La adhesión a las guías clínicas.
13. El problema de la adherencia terapéutica.
14. Identificación de nuevos factores de riesgo vascular y de la influencia del estrés como marcador de riesgo de ictus.
15. Identificación de poblaciones diana de muy alto riesgo vascular en las que hacer prevención.
16. Métodos de evaluación de la función renal.
17. Epidemiología de la insuficiencia renal.
18. Validación de métodos pronósticos en insuficiencia renal.
P02. ENFERMEDADES CRÓNICAS, ENVEJECIMIENTO Y NUTRICIÓN HUMANA
Fundamentación
Dentro de los retos sociales que se plantea la Unión Europea resaltan con nitidez aquellos vinculados con las enfermedades crónicas, el envejecimiento, la calidad de vida y los hábitos de vida saludables. Durante décadas el envejecimiento fue asumido como una enfermedad y no como un proceso progresivo habitual en la especie humana que podía o no ir acompañado de enfermedad. Diversos estudios muestran que existe la posibilidad de tener un envejecimiento saludable a través de una vida activa que estimule la práctica de actividad física ajustada a la edad y posibilidades de cada individuo. El Programa de Enfermedades Crónicas, Envejecimiento y Nutrición Humana tiene en cuenta a través de sus diferentes capítulos aquellas enfermedades más prevalentes y las comorbilidades propias del envejecimiento; también dedicará parte importante de su esfuerzo a la educación del individuo, todo dirigido a una vejez activa ajustada a sus posibilidades físicas: se buscará personalizar las indicaciones médicas y la práctica multidisciplinar de atención a los mayores. Asimismo, se profundizará en aquellos aspectos relevantes de las enfermedades crónicas de los sistemas cardiovascular, respiratorio, renal que tanto determinan la situación del paciente mayor, así como los factores favorecedores de ingresos y frecuentación sanitaria que tienen también impacto en los sistemas de salud.
Líneas de Investigación
01. Psicobiología y Psicofarmacología.
02. Investigación clínica en Reumatología, Nefrología, Enfermedades Raras, Depresión, Esquizofrenia, Hipertensión, Neurología, Reumatología, Reproducción, Cáncer, Cardiovascular.
03. Diagnóstico y tratamiento de las apneas de sueño.
04. Tratamiento con ventilación no invasiva en agudos y crónicos.
05. Diagnóstico y tratamiento del cáncer de pulmón.
06. Diagnóstico telemático en patología respiratoria.
07. Tabaquismo y EPOC.
08. Apneas del sueño y enfermedad cardiovascular.
09. Síndrome de hipoventilación y obesidad.
10. Educación en salud, difusión de hábitos de vida saludables: nutrición y actividad física.
11. Trastornos endocrino-metabólicos: obesidad, síndrome metabólico y diabetes.
12. Funciones de riesgo cardiovascular.
13. Insuficiencia cardiaca, infarto de miocardio, fibrilación auricular.
14. La anticoagulación en la fibrilación auricular.
15. Identificación de poblaciones con alto riesgo de reingresos.
16. Identificación de poblaciones con alto riesgo de mortalidad precoz.
17. Aspectos relacionados con el pronóstico de la insuficiencia cardiaca, la cardiopatía isquémica, fibrilación auricular y con la calidad de vida.
18. Investigación, propuestas y validación de escalas predictivas de pronóstico.
19. Análisis de mecanismos de protección no farmacológicos en la fase aguda del ictus.
20. Análisis del efecto de la inmunodepresión en la fase aguda del ictus y el papel de la nutrición en ese escenario clínico.
21. Estudio de los aspectos relacionados con el pronóstico de la enfermedad cerebrovascular y con la calidad de vida.
22. Validación de escalas predictivas de pronostico funcional fundamentalmente usando técnicas de neuroimagen.
23. Enfermedad renal asociada a la diabetes mellitus.
24. Enfermedad renal asociada a la hipertensión arterial.
25. Definición de enfermedad renal en el anciano.
26. Hipertensión arterial en la enfermedad renal.
27. Búsqueda de agentes neuroprotectores (especialmente basados en productos de interés regional).
28. Envejecimiento y patologías relacionadas con las respuestas e interacción inflamación/estrés: síndrome metabólico, fibromialgia, osteoartritis, cáncer. Estrategias preventivas/terapéuticas (actividad física, nutrición, balneoterapia).
29. Proyectos de Investigación y Ensayos Clínicos en Oncología, Oncología Pediátrica, Neumología, Nefrología, Urgencias, Neurología, Medicina Interna, Medicina de Familia y Psiquiatría.
P03. MEDICINA Y TERAPÉUTICA PERSONALIZADAS
Fundamentación
El objetivo fundamental de este Programa de Investigación en la personalización de la terapéutica, tanto la farmacológica como no farmacológica. Si bien la prescripción de medicamentos ha sido el fundamento de la terapéutica, en el siglo XXI es necesario plantearse otros factores relevantes para el mantenimiento de la salud.
Tradicionalmente la Medicina Personalizada o de Precisión se ha basado en el uso de marcadores moleculares (genéticos), la farmacogenética es hoy en día una realidad no solo a nivel de investigación, sino también clínico y regulatorio. La Agencia Europea del Medicamento, en una revisión reciente, ha determinado que el 32 % de los fármacos evaluados por el procedimiento centralizado europeo contienen un biomarcador genético en sus Fichas Técnicas (SmPC). Por tanto, esta línea aspira a la realización de proyectos para la implementación de la Medicina Personalizada en el Servicio Público de Salud en sus diversas especialidades y a su evaluación.
Líneas de Investigación
01. Metodología Farmacogenética Clínica y Medicina Personalizada.
02. Medicina Personalizada en Salud Mental.
03. Medicina Personalizada en Enfermedades Respiratorias.
04. Medicina Personalizada en Enfermedades Cardiológicas.
05. Medicina Personalizada en Enfermedades Vasculares.
06. Medicina Personalizada en Enfermedades Nefrológicas.
07. Medicina Personalizada en Enfermedades Neurológicas.
08. Medicina Personalizada en Enfermedades Infecciosas.
09. Medicina Personalizada en Oncología.
10. Marcadores genéticos de daño renal.
11. Farmacología Clínica y Farmacogenética Clínica aplicada a Proyectos y Ensayos.
P04. MECANISMOS CELULARES Y MOLECULARES DE LA ENFERMEDAD
Fundamentación
El Programa de Bases Celulares y Moleculares de la Enfermedad pretende abordar de manera comprehensiva los procesos y mecanismos que subyacen a patologías relevantes no solo desde el punto de vista sanitario, sino de bienestar social en general. El conocimiento de los fundamentos y bases moleculares que determinan el cambio de una situación fisiológica a una patológica es esencial y, con este programa, se pretende además validar el conocimiento adquirido en sistemas complejos y trasladarlo al estudio de pacientes. La visión global generada por el programa hará posible el diseño de nuevas herramientas diagnósticas y pronósticas que permitan una detección más temprana de la enfermedad y una previsión más acertada de su evolución. Todo ello tendrá como objetivo último la generación de terapias más efectivas, con menores efectos secundarios y más personalizadas. Este programa se integra en su totalidad con el resto de los incluidos en el INUBE dada su transversalidad con la investigación clínica, cronificación de la enfermedad, medicina personalizada y bioingeniería en la búsqueda de terapias avanzadas de última generación.
Líneas de Investigación
01. Exploración de distintos aspectos traslacionales del ictus.
02. Biomarcadores en las enfermedades renales.
03. Etiología molecular del Parkinson.
04. Autofagia.
05. Neurodegeneración y neuroprotección.
06. Efecto de plaguicidas.
07. Efecto mutaciones en genes relacionados con la enfermedad de Parkinson.
08. Aproximaciones proteómicas, genómicas, transcriptómicas y metabolómicas.
09. Búsqueda de biomarcadores diagnóstico y pronóstico.
10. Crecimiento tumoral.
11. Metástasis.
12. Angiogénesis.
13. Células madre tumorales.
14. Interacción tumor-estroma.
15. Mutaciones y genética tumoral.
16. Genómica, transcriptómica, metabolómica.
17. Marcadores diagnósticos y dianas terapéuticas en hepatocarcinoma, melanoma, glioblastoma.
18. Neuroinmunomodulación: Interacción respuestas inflamatorias y de estrés.
19. Hormonas, neuromoduladores y proteínas de estrés (catecolaminas, glucocorticoides, proteínas HSP70).
20. Inmunidad humoral (citoquinas y mediadores inflamatorios) e inmunidad celular innata (macrófagos, monocitos, células dendríticas, células NK, neutrófilos).
21. Biomarcadores diagnósticos de respuestas inflamación/estrés.
P05. BIOMATERIALES Y BIOINGENIERÍA
Fundamentación
Los materiales empleados en biomedicina han dejado de ser exclusivamente elementos estructurales para transformarse en sistemas inteligentes capaces de interactuar con el medio. Las características topográficas, físicas y bioquímicas de la superficie de los diferentes dispositivos pueden ser manipuladas para lograr los objetivos buscados, que van desde favorecer la proliferación celular sobre un implante procurándolo antibacteriano, evitar la adsorción de macromoléculas sobre un stent, liberar de manera controlada medicamentos o bien mantener elementos para análisis sobre un microchip. En el Programa de Biomateriales y Bioingeniería se pretende incorporar la investigación en desarrollos tecnológicos para mejorar la calidad de vida de pacientes, especialmente mediante la caracterización y desarrollo de materiales para dispositivos con superficies con propiedades cada vez más ajustadas a la especificidad de la posible patología o a la edad del paciente. Este acercamiento a la problemática real se logra por el acoplamiento transversal con otras Líneas de Investigación de INUBE, como las referidas a enfermedades cardiovasculares, respiratorias y endocrinas. Se plantea un foco de atención especial hacia los procesos infecciosos, particularmente relacionados con la presencia de estos materiales en el paciente, y hacia la identificación de opciones al uso de antibióticos para prevención de estas infecciones.
Líneas de Investigación
01. Profundizar en la validación científica de las nuevas tecnologías para empoderar y ayudar al paciente crónico.
02. Adherencia y patogenicidad microbiana.
03. Evaluación, caracterización y prevención de la adhesión y formación de biofilms de microorganismos a superficies.
04. Identificación de moléculas de productos naturales con alto potencial terapéutico para la inhibición de biofilms o atenuación de su patogenicidad.
05. Caracterización de superficies de biomateriales.